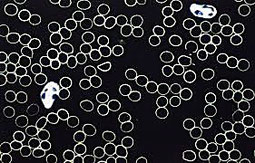

dunkelfeldmikroskopie
Dunkelfeldmikroskopie in zürich

Bei der Dunkelfeldmikroskopie wird das "lebendige" Blut, also nicht wie sonst üblich, ein getrocknetes Präparat, direkt unter dem Mikroskop im Dunkelfeld betrachtet und analysiert.
Die Diagnostik mit Dunkelfeld-Blutbildern sowie das daraus abgeleitete Therapieverfahren Isopathie wurde von Prof. Dr. Günther Enderlein (1872 - 1968) entwickelt. Mit der Dunkelfeldmikroskopie
wird in erster Linie die Vitalität des Blutes und die Qualität der Blutbestandteile angeschaut.
Dieses Verfahren kann wichtige Hinweise zu
- Milieuveränderungen
- Übersäuerungen
- Gerinnungsstörungen
- Sauerstoffmangelzuständen
- Anämien
- Belastungen durch Erreger
liefern.
Naturheilpraxis Irène Nabi, Dunkelfeldmikroskopie in Zürich

Naturheilpraxis Irène Nabi
Schaffhauserstrasse 6
8006 Zürich
078 784 10 25
naturheilpraxis.nabi@gmx.ch
www.naturheilpraxis-nabi.ch
Facebook: Naturheilpraxis Irène Nabi
Instagram: nabi_naturheilpraxis sowie praxisgarten